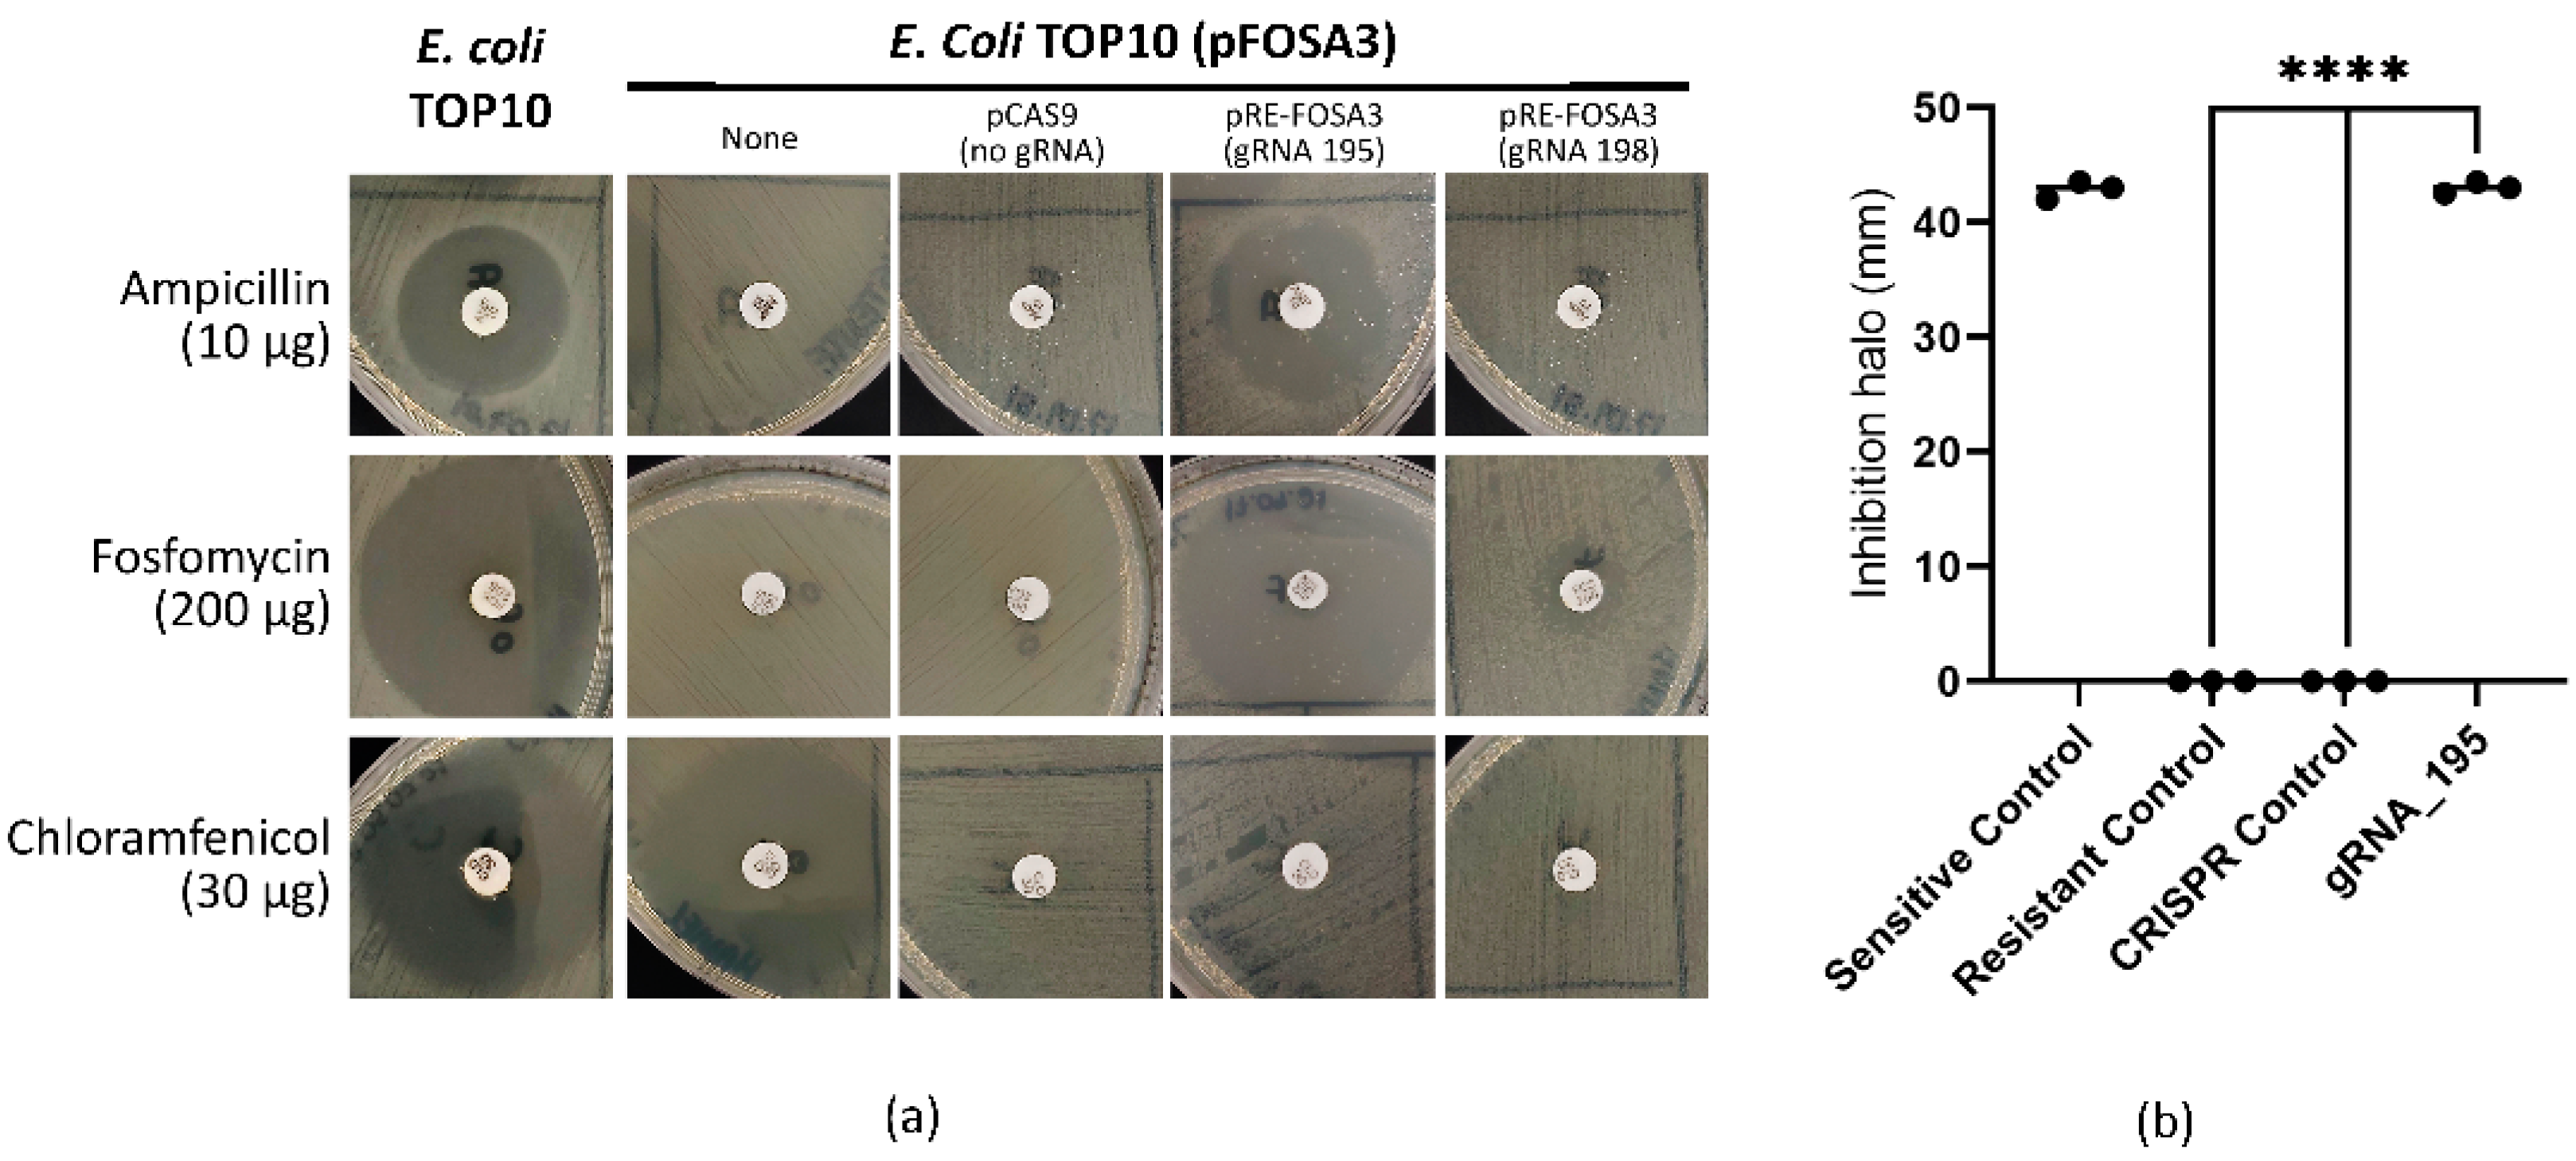
Ijms 23 09175 g003

Resensitization of Fosfomycin-Resistant Escherichia coli Using the CRISPR System
Abstract
:1. Introduction
2. Results
2.1. Analysis of the Occurrence of fosA Genes in Bacteria
2.2. Generation of a Fosfomycin-Resistant E. coli Strain
2.3. pFOSA3+ E. coli Resistance Reversal
3. Discussion
4. Materials and Methods
4.1. Analysis of the Occurrence of fosA Genes in Bacteria
4.2. Analysis of the fosA3 DNA and Protein Sequences
4.3. Design of gRNAs Targeting fosA3
4.4. pRE-FOSA3 Assembly
4.5. Generation of an E. coli Fosfomycin-Resistant Strain
4.6. Resensitization of E. coli pFOSA3+ with pRE-FOSA3
4.7. Disk Diffusion
4.8. Growth Curve
4.9. Statistical Analysis
Supplementary Materials
Author Contributions
Funding
Data Availability Statement
Acknowledgments
Conflicts of Interest
References
- McCue, J.D. Gram-negative bacillary bacteremia in the elderly: Incidence, ecology, etiology, and mortality. J. Am. Geriatr. Soc. 1987, 35, 213–218. [Google Scholar] [CrossRef] [PubMed]
- Mylotte, J.M.; Tayara, A.; Goodnough, S. Epidemiology of bloodstream infection in nursing home residents: Evaluation in a large cohort from multiple homes. Clin. Infect. Dis. 2002, 35, 1484–1490. [Google Scholar] [CrossRef] [PubMed]
- Jain, S.; Self, W.H.; Wunderink, R.G.; Fakhran, S.; Balk, R.; Bramley, A.M.; Reed, C.; Grijalva, C.G.; Anderson, E.J.; Courtney, D.M.; et al. CDC EPIC Study Team Community-Acquired Pneumonia Requiring Hospitalization among U.S. Adults. N. Engl. J. Med. 2015, 373, 415–427. [Google Scholar] [CrossRef] [PubMed]
- Mueller, M.; Tainter, C.R. Escherichia Coli. In StatPearls; StatPearls Publishing: Treasure Island, FL, USA, 2022. [Google Scholar]
- Terlizzi, M.E.; Gribaudo, G.; Maffei, M.E. UroPathogenic Escherichia coli (UPEC) Infections: Virulence Factors, Bladder Responses, Antibiotic, and Non-antibiotic Antimicrobial Strategies. Front. Microbiol. 2017, 8, 1566. [Google Scholar] [CrossRef] [PubMed]
- Hendlin, D.; Stapley, E.O.; Jackson, M.; Wallick, H.; Miller, A.K.; Wolf, F.J.; Miller, T.W.; Chaiet, L.; Kahan, F.M.; Foltz, E.L.; et al. Phosphonomycin, a new antibiotic produced by strains of streptomyces. Science 1969, 166, 122–123. [Google Scholar] [CrossRef]
- Shoji, J.; Kato, T.; Hinoo, H.; Hattori, T.; Hirooka, K.; Matsumoto, K.; Tanimoto, T.; Kondo, E. Production of fosfomycin (phosphonomycin) by Pseudomonas syringae. J. Antibiot. 1986, 39, 1011–1012. [Google Scholar] [CrossRef] [PubMed]
- Skarzynski, T.; Mistry, A.; Wonacott, A.; Hutchinson, S.E.; Kelly, V.A.; Duncan, K. Structure of UDP-N-acetylglucosamine enolpyruvyl transferase, an enzyme essential for the synthesis of bacterial peptidoglycan, complexed with substrate UDP-N-acetylglucosamine and the drug fosfomycin. Structure 1996, 4, 1465–1474. [Google Scholar] [CrossRef]
- Silver, L.L. Fosfomycin: Mechanism and resistance. Cold Spring Harb. Perspect. Med. 2017, 7, a025new262. [Google Scholar] [CrossRef] [PubMed]
- Castañeda-García, A.; Blázquez, J.; Rodríguez-Rojas, A. Molecular mechanisms and clinical impact of acquired and intrinsic fosfomycin resistance. Antibiotics 2013, 2, 217–236. [Google Scholar] [CrossRef]
- Ito, R.; Mustapha, M.M.; Tomich, A.D.; Callaghan, J.D.; McElheny, C.L.; Mettus, R.T.; Shanks, R.M.Q.; Sluis-Cremer, N.; Doi, Y. Widespread Fosfomycin Resistance in Gram-Negative Bacteria Attributable to the Chromosomal fosA Gene. MBio 2017, 8, e00749-17. [Google Scholar] [CrossRef]
- Ito, R.; Pacey, M.P.; Mettus, R.T.; Sluis-Cremer, N.; Doi, Y. Origin of the plasmid-mediated fosfomycin resistance gene fosA3. J. Antimicrob. Chemother. 2018, 73, 373–376. [Google Scholar] [CrossRef] [PubMed]
- Loras, C.; Mendes, A.C.; Peixe, L.; Novais, Â.; Alós, J.-I. Escherichia coli resistant to fosfomycin from urinary tract infections: Detection of the fosA3 gene in Spain. J. Glob. Antimicrob. Resist. 2020, 21, 414–416. [Google Scholar] [CrossRef] [PubMed]
- Cheng, K.; Fang, L.-X.; Ge, Q.-W.; Wang, D.; He, B.; Lu, J.-Q.; Zhong, Z.-X.; Wang, X.-R.; Yu, Y.; Lian, X.-L.; et al. Emergence of fosA3 and blaCTX-M-14 in Multidrug-Resistant Citrobacter freundii Isolates From Flowers and the Retail Environment in China. Front. Microbiol. 2021, 12, 586504. [Google Scholar] [CrossRef] [PubMed]
- Munita, J.M.; Arias, C.A. Mechanisms of antibiotic resistance. Microbiol. Spectr. 2016, 4, 15. [Google Scholar] [CrossRef] [PubMed]
- Llor, C.; Bjerrum, L. Antimicrobial resistance: Risk associated with antibiotic overuse and initiatives to reduce the problem. Ther. Adv. Drug Saf. 2014, 5, 229–241. [Google Scholar] [CrossRef]
- Ventola, C.L. The antibiotic resistance crisis: Part 1: Causes and threats. Pharm. Ther. 2015, 40, 277–283. [Google Scholar]
- O’Neill, J. Tackling drug-resistant infections globally: Final report and recommendations. J. Am. Geriatr. Soc. 2016, 35, 213–218. [Google Scholar]
- Kim, J.-S.; Cho, D.-H.; Park, M.; Chung, W.-J.; Shin, D.; Ko, K.S.; Kweon, D.-H. CRISPR/Cas9-Mediated Re-Sensitization of Antibiotic-Resistant Escherichia coli Harboring Extended-Spectrum β-Lactamases. J. Microbiol. Biotechnol. 2016, 26, 394–401. [Google Scholar] [CrossRef]
- Shabbir, M.A.B.; Shabbir, M.Z.; Wu, Q.; Mahmood, S.; Sajid, A.; Maan, M.K.; Ahmed, S.; Naveed, U.; Hao, H.; Yuan, Z. CRISPR-cas system: Biological function in microbes and its use to treat antimicrobial resistant pathogens. Ann. Clin. Microbiol. Antimicrob. 2019, 18, 21. [Google Scholar] [CrossRef]
- Hao, M.; He, Y.; Zhang, H.; Liao, X.-P.; Liu, Y.-H.; Sun, J.; Du, H.; Kreiswirth, B.N.; Chen, L. CRISPR-Cas9-Mediated Carbapenemase Gene and Plasmid Curing in Carbapenem-Resistant Enterobacteriaceae. Antimicrob. Agents Chemother. 2020, 64, e00843-20. [Google Scholar] [CrossRef]
- Tagliaferri, T.L.; Guimarães, N.R.; Pereira, M. de P.M.; Vilela, L.F.F.; Horz, H.-P.; Dos Santos, S.G.; de Oliveira Mendes, T.A. Exploring the Potential of CRISPR-Cas9 Under Challenging Conditions: Facing High-Copy Plasmids and Counteracting Beta-Lactam Resistance in Clinical Strains of Enterobacteriaceae. Front. Microbiol. 2020, 11, 578. [Google Scholar] [CrossRef] [PubMed]
- Li, Y.; Peng, N. Endogenous CRISPR-Cas System-Based Genome Editing and Antimicrobials: Review and Prospects. Front. Microbiol. 2019, 10, 2471. [Google Scholar] [CrossRef] [PubMed]
- Falagas, M.E.; Vouloumanou, E.K.; Samonis, G.; Vardakas, K.Z. Fosfomycin. Clin. Microbiol. Rev. 2016, 29, 321–347. [Google Scholar] [CrossRef] [PubMed]
- Aghamali, M.; Sedighi, M.; Zahedi Bialvaei, A.; Mohammadzadeh, N.; Abbasian, S.; Ghafouri, Z.; Kouhsari, E. Fosfomycin: Mechanisms and the increasing prevalence of resistance. J. Med. Microbiol. 2019, 68, 11–25. [Google Scholar] [CrossRef] [PubMed]
- Foxman, B. The epidemiology of urinary tract infection. Nat. Rev. Urol. 2010, 7, 653–660. [Google Scholar] [CrossRef]
- Antinori, S.; Pezzani, M.D. Uncomplicated and complicated urinary tract infections in adults: The infectious diseases’s specialist perspective. In Imaging and Intervention in Urinary Tract Infections and Urosepsis; Tonolini, M., Ed.; Springer International Publishing: Cham, Switzerland, 2018; pp. 17–33. ISBN 978-3-319-68275-4. [Google Scholar]
- Jiang, W.; Men, S.; Kong, L.; Ma, S.; Yang, Y.; Wang, Y.; Yuan, Q.; Cheng, G.; Zou, W.; Wang, H. Prevalence of Plasmid-Mediated Fosfomycin Resistance Gene fosA3 Among CTX-M-Producing Escherichia coli Isolates from Chickens in China. Foodborne Pathog. Dis. 2017, 14, 210–218. [Google Scholar] [CrossRef]
- Zurfluh, K.; Treier, A.; Schmitt, K.; Stephan, R. Mobile fosfomycin resistance genes in Enterobacteriaceae-An increasing threat. Microbiologyopen 2020, 9, e1135. [Google Scholar] [CrossRef]
- Khor, W.P.; Olaoye, O.; D’Arcy, N.; Krockow, E.M.; Elshenawy, R.A.; Rutter, V.; Ashiru-Oredope, D. The Need for Ongoing Antimicrobial Stewardship during the COVID-19 Pandemic and Actionable Recommendations. Antibiotics 2020, 9, 904. [Google Scholar] [CrossRef]
- Ashiru-Oredope, D.; Kerr, F.; Hughes, S.; Urch, J.; Lanzman, M.; Yau, T.; Cockburn, A.; Patel, R.; Sheikh, A.; Gormley, C.; et al. Assessing the Impact of COVID-19 on Antimicrobial Stewardship Activities/Programs in the United Kingdom. Antibiotics 2021, 10, 110. [Google Scholar] [CrossRef]
- Ghosh, S.; Bornman, C.; Zafer, M.M. Antimicrobial Resistance Threats in the emerging COVID-19 pandemic: Where do we stand? J. Infect. Public Health 2021, 14, 555–560. [Google Scholar] [CrossRef]
- Yang, T.-Y.; Lu, P.-L.; Tseng, S.-P. Update on fosfomycin-modified genes in Enterobacteriaceae. J. Microbiol. Immunol. Infect. 2019, 52, 9–21. [Google Scholar] [CrossRef] [PubMed]
- Cao, X.L.; Shen, H.; Xu, Y.Y.; Xu, X.J.; Zhang, Z.F.; Cheng, L.; Chen, J.H.; Arakawa, Y. High prevalence of fosfomycin resistance gene fosA3 in bla CTX-M-harbouring Escherichia coli from urine in a Chinese tertiary hospital during 2010-2014. Epidemiol. Infect. 2017, 145, 818–824. [Google Scholar] [CrossRef] [PubMed]
- Cyoia, P.S.; Koga, V.L.; Nishio, E.K.; Houle, S.; Dozois, C.M.; de Brito, K.C.T.; de Brito, B.G.; Nakazato, G.; Kobayashi, R.K.T. Distribution of ExPEC Virulence Factors, blaCTX-M, fosA3, and mcr-1 in Escherichia coli Isolated From Commercialized Chicken Carcasses. Front. Microbiol. 2018, 9, 3254. [Google Scholar] [CrossRef] [PubMed]
- Fernandes, M.R.; Sellera, F.P.; Moura, Q.; Souza, T.A.; Lincopan, N. Draft genome sequence of a CTX-M-8, CTX-M-55 and FosA3 co-producing Escherichia coli ST117/B2 isolated from an asymptomatic carrier. J. Glob. Antimicrob. Resist. 2018, 12, 183–184. [Google Scholar] [CrossRef]
- Lv, L.; Huang, X.; Wang, J.; Huang, Y.; Gao, X.; Liu, Y.; Zhou, Q.; Zhang, Q.; Yang, J.; Guo, J.-Y.; et al. Multiple Plasmid Vectors Mediate the Spread of fosA3 in Extended-Spectrum-β-Lactamase-Producing Enterobacterales Isolates from Retail Vegetables in China. mSphere 2020, 5, e00507-20. [Google Scholar] [CrossRef]
- Biggel, M.; Zurfluh, K.; Treier, A.; Nüesch-Inderbinen, M.; Stephan, R. Characteristics of fosA-carrying plasmids in E. coli and Klebsiella spp. isolates originating from food and environmental samples. J. Antimicrob. Chemother. 2021, 76, 2004–2011. [Google Scholar] [CrossRef]
- Han, L.; Lu, X.-Q.; Liu, X.-W.; Liao, M.-N.; Sun, R.-Y.; Xie, Y.; Liao, X.-P.; Liu, Y.-H.; Sun, J.; Zhang, R.-M. Molecular Epidemiology of Fosfomycin Resistant E. coli from a Pigeon Farm in China. Antibiotics 2021, 10, 777. [Google Scholar] [CrossRef]
- de Souza, G.L.E.; Medeiros, L.P.; Dibo, M.; Nishio, E.K.; Koga, V.L.; Gonçalves, B.C.; Grassotti, T.T.; de Camargo, T.C.L.; Pinheiro, J.J.; Vespero, E.C.; et al. Detection of ESBL/AmpC-Producing and Fosfomycin-Resistant Escherichia coli From Different Sources in Poultry Production in Southern Brazil. Front. Microbiol. 2020, 11, 604544. [Google Scholar] [CrossRef]
- Labun, K.; Montague, T.G.; Krause, M.; Torres Cleuren, Y.N.; Tjeldnes, H.; Valen, E. CHOPCHOP v3: Expanding the CRISPR web toolbox beyond genome editing. Nucleic Acids Res. 2019, 47, W171–W174. [Google Scholar] [CrossRef]
- Fu, Y.; Foden, J.A.; Khayter, C.; Maeder, M.L.; Reyon, D.; Joung, J.K.; Sander, J.D. High-frequency off-target mutagenesis induced by CRISPR-Cas nucleases in human cells. Nat. Biotechnol. 2013, 31, 822–826. [Google Scholar] [CrossRef]
- Fu, Y.; Sander, J.D.; Reyon, D.; Cascio, V.M.; Joung, J.K. Improving CRISPR-Cas nuclease specificity using truncated guide RNAs. Nat. Biotechnol. 2014, 32, 279–284. [Google Scholar] [CrossRef] [PubMed]
- Koike-Yusa, H.; Li, Y.; Tan, E.-P.; Velasco-Herrera, M.D.C.; Yusa, K. Genome-wide recessive genetic screening in mammalian cells with a lentiviral CRISPR-guide RNA library. Nat. Biotechnol. 2014, 32, 267–273. [Google Scholar] [CrossRef] [PubMed]
- Chari, R.; Mali, P.; Moosburner, M.; Church, G.M. Unraveling CRISPR-Cas9 genome engineering parameters via a library-on-library approach. Nat. Methods 2015, 12, 823–826. [Google Scholar] [CrossRef] [PubMed]
- Moreno-Mateos, M.A.; Vejnar, C.E.; Beaudoin, J.-D.; Fernandez, J.P.; Mis, E.K.; Khokha, M.K.; Giraldez, A.J. CRISPRscan: Designing highly efficient sgRNAs for CRISPR-Cas9 targeting in vivo. Nat. Methods 2015, 12, 982–988. [Google Scholar] [CrossRef]
- Chuai, G.-H.; Wang, Q.-L.; Liu, Q. In silico meets in vivo: Towards computational CRISPR-based sgRNA design. Trends Biotechnol. 2017, 35, 12–21. [Google Scholar] [CrossRef]
- You, Q.; Zhong, Z.; Ren, Q.; Hassan, F.; Zhang, Y.; Zhang, T. CRISPRMatch: An Automatic Calculation and Visualization Tool for High-throughput CRISPR Genome-editing Data Analysis. Int. J. Biol. Sci. 2018, 14, 858–862. [Google Scholar] [CrossRef]
- Ren, Q.; Zhong, Z.; Wang, Y.; You, Q.; Li, Q.; Yuan, M.; He, Y.; Qi, C.; Tang, X.; Zheng, X.; et al. Bidirectional Promoter-Based CRISPR-Cas9 Systems for Plant Genome Editing. Front. Plant Sci. 2019, 10, 1173. [Google Scholar] [CrossRef]
- Liu, G.; Zhang, Y.; Zhang, T. Computational approaches for effective CRISPR guide RNA design and evaluation. Comput. Struct. Biotechnol. J. 2020, 18, 35–44. [Google Scholar] [CrossRef]
- Bikard, D.; Euler, C.W.; Jiang, W.; Nussenzweig, P.M.; Goldberg, G.W.; Duportet, X.; Fischetti, V.A.; Marraffini, L.A. Exploiting CRISPR-Cas nucleases to produce sequence-specific antimicrobials. Nat. Biotechnol. 2014, 32, 1146–1150. [Google Scholar] [CrossRef]
- Edgar, R.C. MUSCLE: Multiple sequence alignment with high accuracy and high throughput. Nucleic Acids Res. 2004, 32, 1792–1797. [Google Scholar] [CrossRef]
- Waterhouse, A.M.; Procter, J.B.; Martin, D.M.A.; Clamp, M.; Barton, G.J. Jalview Version 2—A multiple sequence alignment editor and analysis workbench. Bioinformatics 2009, 25, 1189–1191. [Google Scholar] [CrossRef] [PubMed]
- Jiang, W.; Bikard, D.; Cox, D.; Zhang, F.; Marraffini, L.A. RNA-guided editing of bacterial genomes using CRISPR-Cas systems. Nat. Biotechnol. 2013, 31, 233–239. [Google Scholar] [CrossRef] [PubMed]

| Antibiotics | Diameter Zone (mm) | ||||
|---|---|---|---|---|---|
| E. coli TOP10 | E. coli TOP10 (pFOSA3+) | ||||
| None | pCAS9 (Without gRNA) | pRE-FOSA3 (gRNA_195) | pRE_FOSA3 (gRNA_198) ** | ||
| Ampicillin (10 μg) | 23 (±0.29) | 0 | 0 | 24 (±0.5) | 0 |
| Fosfomycin (200 μg) * | 42 (±0.58) | 0 | 0 | 44 (±0.5) | 15 |
| Chloramphenicol (30 μg) | 34 (±0.86) | 33 (±0.29) | 0 | 0 | 0 |
Publisher’s Note: MDPI stays neutral with regard to jurisdictional claims in published maps and institutional affiliations. |
© 2022 by the authors. Licensee MDPI, Basel, Switzerland. This article is an open access article distributed under the terms and conditions of the Creative Commons Attribution (CC BY) license (https://creativecommons.org/licenses/by/4.0/).
Share and Cite
Walflor, H.S.M.; Lucena, A.R.C.; Tuon, F.F.; Medeiros, L.C.S.; Faoro, H. Resensitization of Fosfomycin-Resistant Escherichia coli Using the CRISPR System. Int. J. Mol. Sci. 2022, 23, 9175. https://doi.org/10.3390/ijms23169175
Walflor HSM, Lucena ARC, Tuon FF, Medeiros LCS, Faoro H. Resensitization of Fosfomycin-Resistant Escherichia coli Using the CRISPR System. International Journal of Molecular Sciences. 2022; 23(16):9175. https://doi.org/10.3390/ijms23169175
Chicago/Turabian StyleWalflor, Haniel Siqueira Mortagua, Aline Rodrigues Castro Lucena, Felipe Francisco Tuon, Lia Carolina Soares Medeiros, and Helisson Faoro. 2022. "Resensitization of Fosfomycin-Resistant Escherichia coli Using the CRISPR System" International Journal of Molecular Sciences 23, no. 16: 9175. https://doi.org/10.3390/ijms23169175
APA StyleWalflor, H. S. M., Lucena, A. R. C., Tuon, F. F., Medeiros, L. C. S., & Faoro, H. (2022). Resensitization of Fosfomycin-Resistant Escherichia coli Using the CRISPR System. International Journal of Molecular Sciences, 23(16), 9175. https://doi.org/10.3390/ijms23169175

